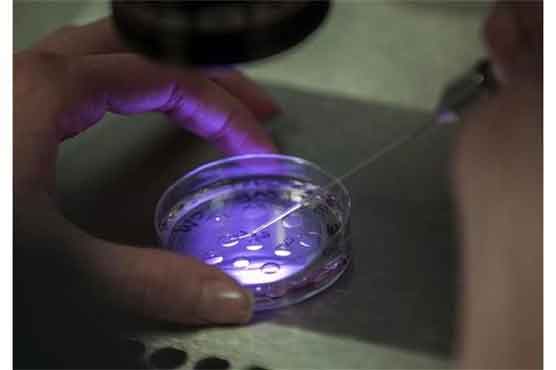
Dunya News

Summary In conventional IVF, expensive, potent drugs that are injected can produce more than 20 eggs.
LONDON (AP) - Since the first test-tube baby was born more than three decades ago, in vitro fertilization has evolved into a highly sophisticated lab procedure. Now, scientists are going back to basics and testing a simpler and cheaper method.
In the West, many would-be parents spend thousands of dollars for IVF, which involves pricey incubators and extensive screening. But European and American scientists say a simplified version of the entire procedure aimed at developing countries could be done for about 200 euros ($265) with generic fertility drugs and basic lab equipment that would fit inside a shoebox.
"IVF is made to sound complicated but the fact is that the early embryo is not very demanding," said Jonathan Van Blerkom, a fertility expert at the University of Colorado.
A human embryo doesn t need much beyond some basic solutions, a steady pH level and constant temperature, he said.
The simpler approach calls for women to take cheaper fertility tablets to stimulate their ovaries to release more than one egg per month. In conventional IVF, expensive, potent drugs that are injected can produce more than 20 eggs.
Van Blerkom developed the simplified technique after European colleagues asked him how IVF could be done in developing countries. "My first reaction was, You ve got to be kidding, " he said.
But with two test tubes and special solutions, "it s possible to generate the exact same conditions, or very similar, to what people are generating in a $60,000 incubator."
One test tube is used to prepare a solution including carbon dioxide, which creates the ideal conditions for fertilization. That s piped into a second tube, where one egg and a few thousand sperm are added, before being placed in a heating block. After about two to three days, any resulting embryo is examined under a microscope before being transferred into the woman.
Van Blerkom and colleagues estimated that about half of all people seeking infertility treatment could potentially be helped by the method. Those who have complicated infertility problems, like men with severe sperm problems or women with very few eggs left, will still need standard IVF.
In an ongoing trial in Belgium, researchers are comparing the techniques. Women under 36 seeking IVF for the first time are given a mild dose of injectable fertility drugs. If at least eight eggs are retrieved, half undergo traditional IVF, and half use the simpler method.
A specialist who doesn t know which technique was used picks the best-looking embryo to be transferred.
For the more than 100 women treated so far, the pregnancy rate was about 34 percent for both methods. So far, 14 babies have been born using the simplified method and 13 babies from traditional IVF.
The World Health Organization estimates there are between 120 and 160 million couples struggling with infertility worldwide.
"Nobody thinks that infertility in developing countries is a problem but it is an even bigger problem there than in (the West)," said Sheryl Vanderpoel, a WHO reproductive health expert.
She said more people in developing countries have complications from untreated infections, including sexually spread diseases, than in the West, which can hurt their fertility.
"Making IVF affordable is a public health priority," she said.
Dr. Hassan Sallam, director of the Alexandria Fertility and IVF Center in Egypt, said the cheaper IVF method would be welcomed. He said there is considerable social pressure on young Egyptian couples to have children and that is compounded by the fact in rural areas, many newlyweds live with the man s family.
"All eyes are on the newlywed couple to see if pregnancy has happened after the first month," he said in an email. He said couples married for two to three months occasionally come to see him "just to please their in-laws."
Although the new IVF strategy is intended for use mainly in developing countries, doctors in rich countries are also interested.
"You should not have to be rich just to have IVF," said Dr. Geeta Nargund, medical director for Create Health Clinics, a private fertility center in London. "There are so many people who cannot afford the treatment (in the West) that there would be huge demand if there were something cheaper available."
In many European countries, national health systems pay for several IVF cycles for eligible couples but it can cost more than $10,000 for those seeking it privately. For many couples, up to three cycles are necessary to create a baby. She has asked Britain s regulatory agency for fertility treatment for permission to test the simpler technique.
Some said the success rates of the cheaper IVF method would likely be lower than those for regular IVF. The simplified method does not include any extensive screening of embryos or any procedures to inject sperm directly into the eggs.
"You aren t producing as many eggs with this (cheap) method so the numbers will not be as high," said Ian Cooke, an emeritus professor of reproductive medicine at Sheffield University. Cooke also thought training enough health professionals in developing countries might be an issue.
Still, he said the method was promising. Because doctors were planning to use less potent fertility drugs, he said it was fine to cut back on the regular screening and daily tests used in normal IVF regimens.
"From a technical point of view, they have proven it works," he said, adding it was now necessary to test the technique in developing countries.
Patient groups said doctors should offer the cheaper IVF method if it is approved.
"IVF is not a one-size-fits-all process," said Susan Seenan, deputy chief executive of Infertility Network UK. "Patients are being told they need all kinds of expensive procedures and this may be a good time to step back and see if that is really the case."





